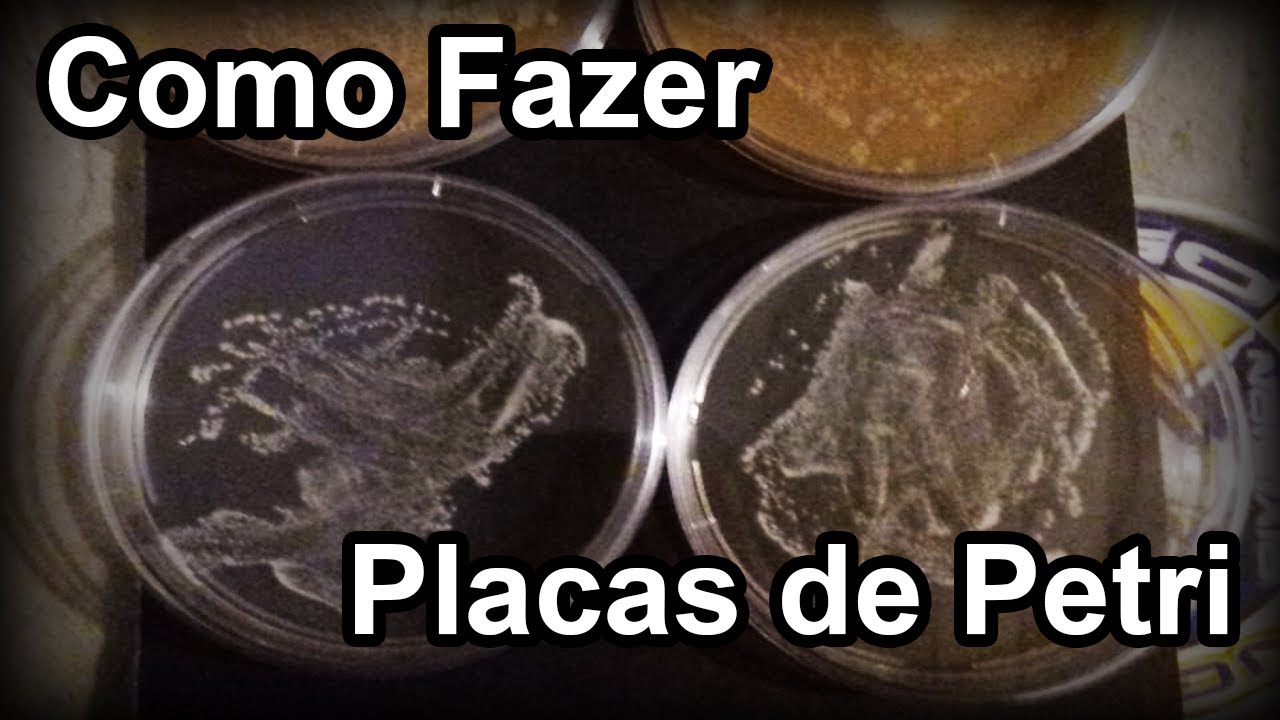
Como Fazer Placas de Petri (+Micro experimento)

Como Fazer Placas de Petri (+Micro experimento)
Автор: Fulminato de Prata
Загружено: 2020-07-04
Просмотров: 13127
Описание: Placas de Petri são excelentes formas de se cultivar micro-organismos, fornecendo um meio sólido para que formem colônias grandes o bastante para observar. No vídeo veremos como fazer placas de Petri utilizando gelatina sem sabor.
Повторяем попытку...
Доступные форматы для скачивания:
Скачать видео
-
Информация по загрузке:



















